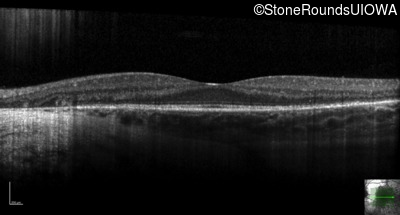
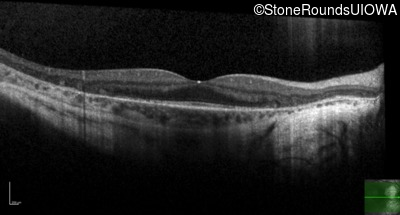
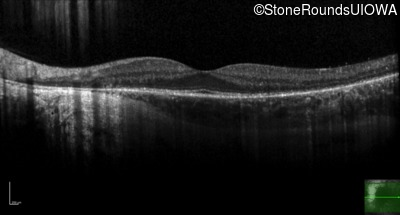
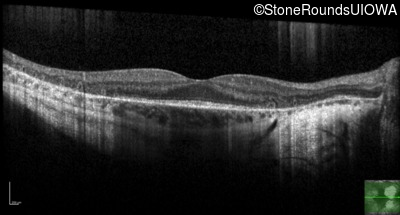
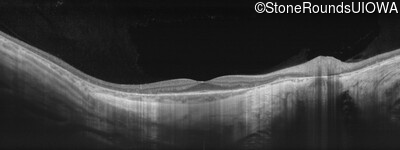
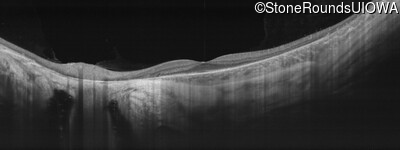
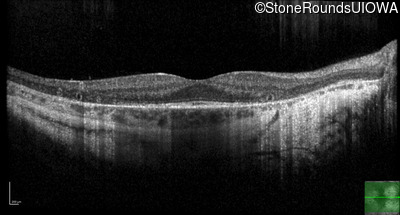
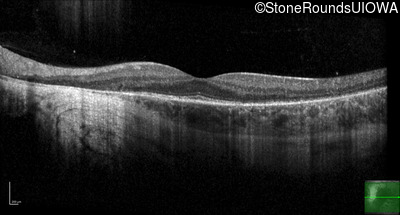
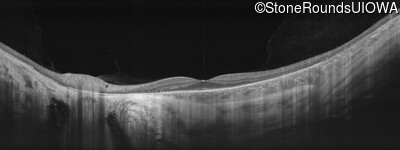
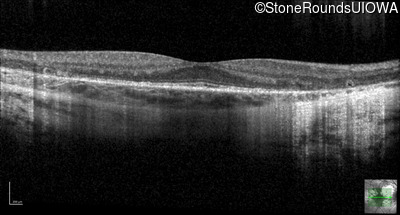
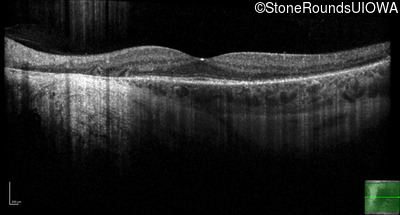

Case
SR431
Student Mode
XL Choroideremia (IIIA1a)
Male
Male
Hidden
SR431
Student Mode
XL Choroideremia (IIIA1a)
Male
Male
Highlighted Images
| Age at visit: 30 years | OD | OS |
|---|---|
History
This 30 year old man has had some difficulty seeing in dim light for the past few years.
| Age at visit: 30 years |
| OD | OS | ||
|---|---|---|---|
| OD | OS | ||
|---|---|---|---|
| OD | OS | ||
|---|---|---|---|
| OD | OS | ||
|---|---|---|---|
| Age at visit: 32 years |
| Age at visit: 34 years |
| Age at visit: 36 years |
Diagnosis & molecular findings
| Disease | Gene | Allele 1 variant(s) | Allele 2 variant(s) | Inheritance mode |
|---|---|---|---|---|
| XL Choroideremia | CHM | Arg253Stop CGA>TGA | XL |